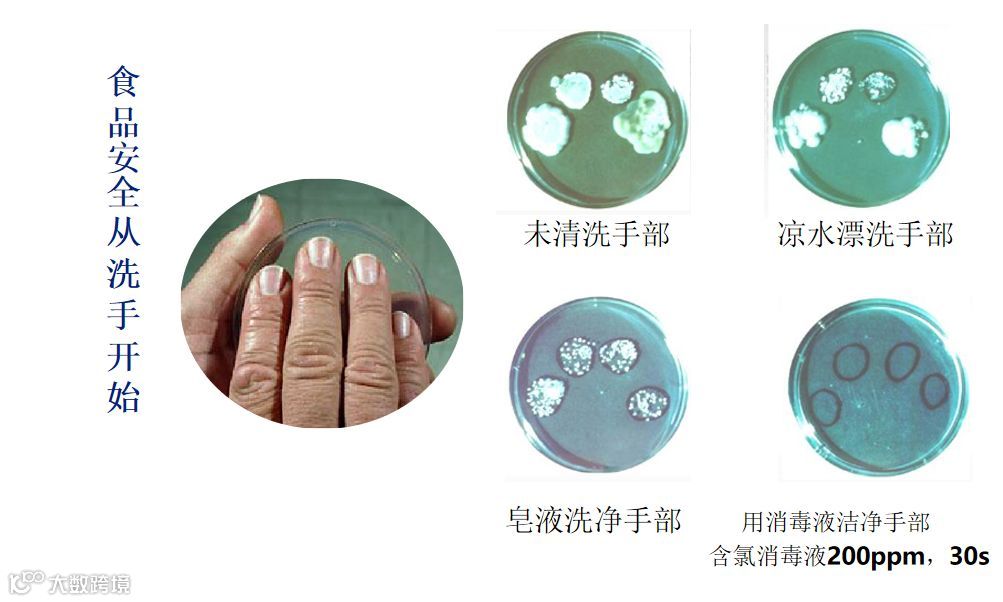

为了切实把好幼儿园食品安全关,做好幼儿膳食营养及食品安全工作,规范幼儿园食堂管理,进一步加强和提高幼儿园食堂食材供货商的安全和责任意识,2019年10月24日中午,鲤跃龙门幼儿园召开食品安全事故防控。

1




会议中,刘璐园长结合《食品安全法实施条例》对幼儿园食品安全管理提出具体要求,并强调:食堂管理人员一定要增强工作责任心,在工作中严把“五大关”,即进货验货关、贮存关、加工关、清消关、个人健康卫生关,对采购食材从源头上把好关,过程上监督,操作上规范。

通过此次会议的召开,进一步加强和提高了食堂工作人员和食材供应商的食品安全意识、责任意识和规范操作意识,推进了鲤跃龙门幼儿园食品安全工作的规范化管理,确保了全园幼儿安全、营养、放心用餐。


1.交幼儿健康体检表原件。
2.交儿童1寸近期彩色照片8张,父母与幼儿合影的2寸近期照片1张。
3.交幼儿预防接种卡复印件。
4.交幼儿户口本复印件(户主页和幼儿姓名页)。
5.家长的身份证复印件(父母)。
教育热线:027-84702738
鲤跃龙门幼儿园欢迎您的到来!




